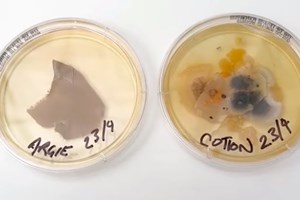
Δωμάτιο ξενοδοχείου vs κάθισμα τουαλέτας, μία πραγματικά βρώμικη σύγκριση - εικόνα 1

Αν κάτι με τρομάζει σε αυτή τη ζωή είναι δίχως αμφιβολία η βρωμιά που δε βλέπει το γυμνό μάτι. Γιατί υπάρχει και το ξέρουμε όλοι. Τα μικρόβια είναι πραγματικά παντού και το ότι δεν τα βλέπουμε, δεν έχει καμία σημασία. Αν είσαι υποχόνδριος ή έχεις μικροβιοφοβίες, μη διαβάσεις αυτό το άρθρο. Ή διάβασέ το απλώς και μόνο για να επιβεβαιώσεις τον μεγάλο σου φόβο.
Μία νέα μελέτη από το USA Today υποστηρίζει πως ακόμη και τα ξενοδοχεία 5 αστέρων μπορεί να έχουν πολύ βρώμικες επιφάνειες — ιδιαίτερα στο μπάνιο αλλά και σε άλλους χώρους που χρησιμοποιούνται από πολλούς, συχνά. Και αυτό συμβαίνει επειδή η καθαριότητα δεν είναι συνώνυμη με την απολύμανση. Μάλιστα, σύμφωνα με ένα πείραμα της WaterFilterGuru.com, εταιρεία εμπειρογνωμόνων στην ποιότητα του νερού, υπάρχουν πολλές επιφάνειες που είναι εξίσου βρώμικες όπως το κάθισμα της τουαλέτας. "Πρόκειται για περιοχές υψηλής κυκλοφορίας που "γεννάνε" μικρόβια λόγω του υγρού περιβάλλοντος. Σκεφτείτε τις οδοντόβουρτσες και τα ξυράφια που κάθονται στους πάγκους του μπάνιου. Όταν το νερό παγιδεύεται, τα βακτήρια θεριεύουν", σημειώνει η Kathleen Wong στην έκθεσή της.
Και τώρα, αν είσαι έτοιμος και θαρραλέος, δες τις πιο αξιοσημείωτες αποκαλύψεις αυτού του τεστ :
> Ο νιπτήρας ενός ξενοδοχείου (το πιο βρώμικο μέρος σε σχεδόν κάθε μπάνιο ξενοδοχείου) είχε πάνω από 55.000 φορές περισσότερα βακτήρια από ένα κάθισμα τουαλέτας.
> Το τηλέφωνο ντους ενός ξενοδοχείου είχε 25.000 φορές περισσότερα βακτήρια από ένα κάθισμα τουαλέτας.
> Η μπανιέρα ενός ξενοδοχείου είχε 40 φορές περισσότερα βακτήρια από ένα κάθισμα τουαλέτας.
Και πίστεψέ με, το καλύτερο δεν το έχεις ακούσει ακόμα. Η ίδια έρευνα υποστηρίζει ότι το μπάνιο ενός σπιτιού που χρησιμοποιείται από μία οικογένεια έχει τρεις φορές περισσότερα βακτήρια από ένα μπάνιο ξενοδοχείου ενώ ο νεροχύτης ενός σπιτιού, έχει στην πραγματικότητα σχεδόν 60.000 φορές περισσότερα βακτήρια από ένα κάθισμα τουαλέτας.
Σιχάθηκες ή όχι ακόμα; Για να σε καθησυχάσουμε πάντως, πρέπει να ομολογήσουμε πως δεν είναι όλα τα βακτήρια το ίδιο επιβλαβή. Εσύ ωστόσο, πλύνε τα χέρια σου και αγόρασε ένα πακέτο με υγρά, αντιβακτηριδιακό μαντηλάκια. Είναι γεγονός πως τα μικρόβια καραδοκούν.
Ακολούθησε το Esquire στο Facebook, το Twitter και το Instagram.